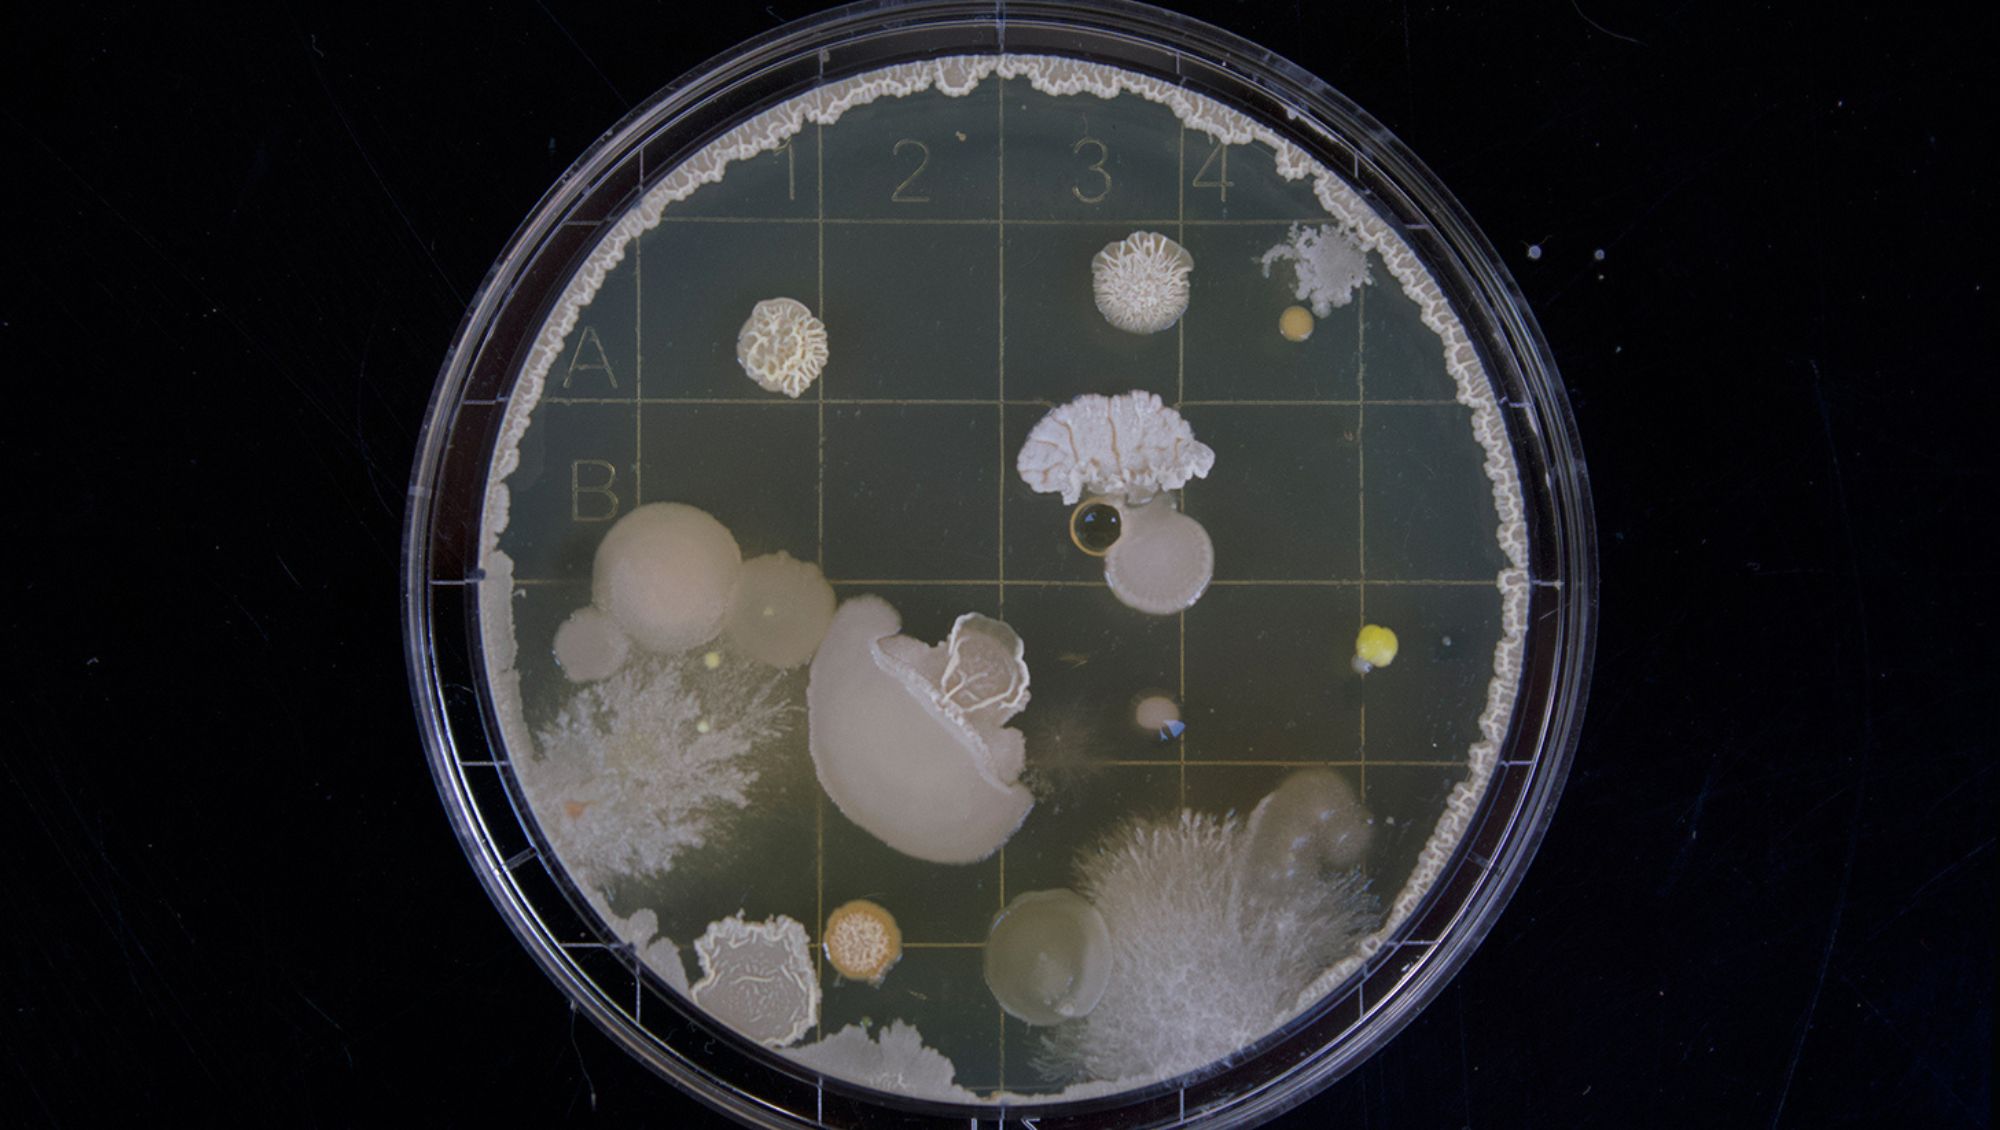
Petri dish culture

Fund a Challenge Prize
Need a solution to a problem? We know a world of problem-solvers who want to help
Support the boldest and bravest ideas
The world is full of problems just waiting to be solved. But solutions can be elusive – slow to materialise and difficult to pin down. Today’s problems need solutions faster.
That’s where we come in. Challenge prizes are a tried and tested method of problem-solving with real impact.
Problem-driven and outcomes-based, challenges support the boldest and bravest ideas to become real, seeing solutions adopted and taken to market.
Where most innovation funding favours options like grants, Challenge Works incentivises and rewards solutions, while supporting the innovators behind them.
Our challenge prize model enables governments, organisations and philanthropic funders an effective way to reach diverse and innovative talent from across the globe.
We believe that systemic change is brought about through radical thinking and collaboration. So we operate where innovation and social impact meet.
Spanning government agencies, consultancies and industry bodies, as well as those seeking solutions to societal problems, like charities and social purpose organisations.
Read on to find out how we could help, or get in touch for more information.
Our Challenge Prizes
Our Current
Our New
Our Broader
What have we done so far
-
0
The number of innovators who’ve competed for our challenge prizes over the past decade. Developing 170 ideas and product prototypes.
-
0
The number of bespoke methods we’ve developed to attract the best innovation talent to your challenge prize. Each one proven to succeed.
-
£0M
The total value of challenge prizes we’ve consulted on.
Of that, £84M are challenge prizes that we’ve run directly.
Who we work with
Governments
We work with governments around the world to design and deliver various challenge prizes.
For example
Our Afri-Plastics Challenge, which is part of the $100-million Marine Litter Mitigation Fund announced by Canadian Prime Minister Trudeau at the G7 summit in 2018.
Corporations
We partner with large corporations to help tackle real-world issues through challenge prizes.
For example
We worked with the UK’s leading banks on our Open Up Challenge, creating next-generation tools and services for the UK’s five million small businesses.
Philanthropic organisations
We collaborate with organisations who want to do good, helping support their philanthropic goals.
For example
Our Global Surgical Training Challenge ran in partnership with Intuitive Foundation, aiming to stimulate the creation of low-cost surgical training modules.
Let’s work together
Discover more of our incredible partner organisations from across the world
If you have a problem, we can help find a solution.
What do we offer?

We use bespoke methods, expert research and design capacity to really get to the root of a problem.

We develop considered, customised and multi-stage challenge prizes to suit our partners’ objectives.

We help to measure the impact of our partners’ work through evaluation data and powerful insights.

We incentivise innovators with access to funding and networks, to support them in going to market.
Our Priorities
-
![Aerial view of flat roofs in India, some painted white to reduce heat absorption]() Creating innovations that help planet earth and its inhabitants tackle the climate crisis.
Creating innovations that help planet earth and its inhabitants tackle the climate crisis. -
![Petri dish culture]()
Global Health
Creating innovations that enable people to prevent, diagnose and treat disease as well as mitigate chronic conditions. -
![Close up of two pairs of hands mid-transaction. Exchanging money for a card with a heart image on it.]()
Resilient Society
Creating innovations that help people participate fully in society by enabling them to access the services, opportunities and networks they need. -
![Man holds a hovering drone on a string in an open space in front of a the city skyline]()
Technology Frontiers
Creating innovations that harness frontier science and technology and direct it towards socially useful goals. -
![A big eyed humanoid robot looks to camera - is it a service droid? - Explorations]()
Explorations
We also work in other areas when we have the opportunity to partner with an inspiring funder or see an opportunity for great impact.
Challenge prize ideas for the future

Aquaculture Revolution Prize
A £10m prize awarded to the team that can invent a digital service that trebles healthy fish production by smallholder farmers in India or Bangladesh. Due to be scaled to at least 50,000 fish farms within three years.

Smart Data for Consumers Prize
A £5m prize awarded to the individual or team able to develop digital products to reduce loyalty penalties. This will be done using smart data and used by vulnerable consumers.

Space Energy Prize
A £30m prize to be awarded to the first team who are able to demonstrate the safe, scalable and reliable transmission of energy between two orbiting satellites launched from a UK spaceport.

Rare Disease Treatment Prize
A £25m prize to be awarded to teams or individuals who work to trial Phase 1 therapeutics in UK patients. Designed to cover conditions in Genomics England’s 20 Priority Therapeutic Areas.

Green Travel Infrastructure Prize
A £10m prize for the first team to demonstrate a reliable solution that can charge and run an electric bus fleet of at least 50 vehicles across a city for a month.